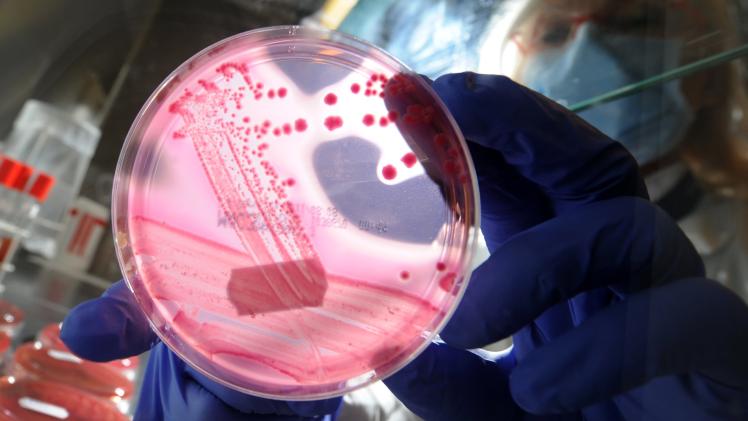

سجل مضاد حيوي جديد، نتائج إيجابية مبشرة في علاج التهابات المسالك البولية، وفق بيانات نشرتها الشركة المطورة للعقار، وأشارت إليها شبكة CNN الأمريكية.
وأظهر العقار الجديد، الذي يُطوّر للمرة الأولى بعد مرور أكثر من 20 عامًا على آخر ترخيص منح لعلاج التهابات المسالك البولية، فعالية كبيرة في علاج المرض.
وبحسب CNN شجعت النتائج الإيجابية، شركة الأدوية المطوّرة للمضاد الحيوي، بالتوقف عن الاختبارات التي تجريها عليه، وستقدم بياناتها قريبًا إلى إدارة الغذاء والدواء الأمريكية لإجازته.
وقالت شركة الأدوية GSK، إن المضاد الحيوي الجديد، المسمّى Gepotidacin، فعال بدرجة مماثلة على الأقل لعقار "نيتروفورانتوين"، الذي يستخدم حاليًا لعلاج عدوى المسالك البولية.
وأعلنت الشركة أنها ستتبع توصية مقدّمة من لجنة مراقبة البيانات المستقلة التابعة لها لإيقاف الدراسة مبكرًا، إذ أن العقار أثبت بالفعل فعاليته، موضحة أنها ستعد نتائجها للنشر في مجلة طبية، وستقدم بياناتها إلى إدارة الغذاء والدواء للموافقة عليه العام المقبل.